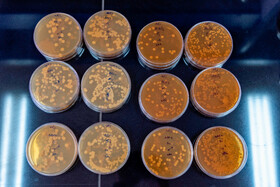
محیط کشت باکتری در آزمایشگاه پروبیوتیک مجتمع تحقیقاتی شهدای جهاددانشگاهی - کرج

مجتمع تحقیقاتی شهدای جهاد دانشگاهی در سال ۱۳۷۰ در فضایی به وسعت حدود ۹۰ هکتار در منطقه هلجرد کرج شروع به فعالیت کرد و همزمان با آمادهسازی هر فضای اداری، خدماتی، آزمایشگاهی و تحقیقاتی، فعالیتهای تخصصی پژوهشکدهها و واحدهای مختلف جهاد دانشگاهی در حوزههای مختلف به تدریج در این مجتمع مستقر شدند. درحال حاضر در این مجتمع تحقیقاتی، ۳ پژوهشکده و ۱۰ مرکز خدمات تخصصی فعالیت میکنند. پارک علم و فناوری البرز هم از ابتدای سال ۱۳۸۷ با مجوز وزارت علوم، تحقیقات و فناوری، فعالیت رسمی خود را در این مجتمع آغاز کرد.

نظرات